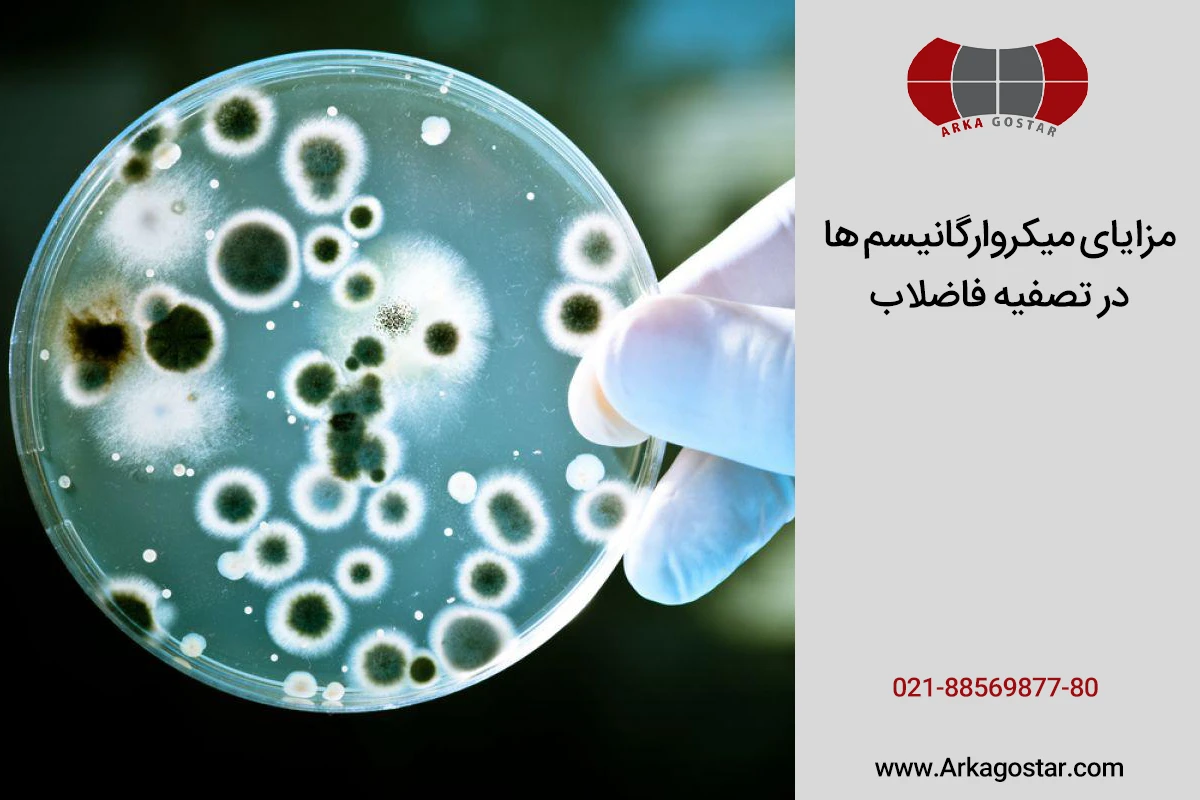
میکروارگانیسم ها در تصفیه فاضلاب چه مزایایی دارند؟

نقش میکروارگانیسم ها در تصفیه فاضلاب
آخرین مقالات
آیا تصفیه فاضلاب آلودگی آب را کاهش می دهد؟
اثرات تصفیه فاضلاب بر سلامت عمومی
آیا پکیج تصفیه فاضلاب در منزل مناسب است؟

بررسی فنی و اقتصادی پکیج تصفیه فاضلاب انسانی

میکروارگانیسم ها در تصفیه فاضلاب اهمیت زیادی دارند و با استفاده از مواد آلی موجود در پسابهای صنعتی و بهداشتی، به نوعی تصفیه بیولوژیکی را انجام میدهند. این میکروارگانیسمها به دستههای مختلفی تقسیم میشوند و هر کدام ویژگیهای ظاهری و ساختار سلولی خاص خود را دارند. شرکت آرکا گستر، که در زمینه تولید پکیج تصفیه فاضلاب و تجهیزات تصفیه آب و فاضلاب فعالیت میکند، در ادامه به معرفی میکروارگانیسمها در تصفیه فاضلاب پرداخته و نقش آنها در حذف مواد آلی را مورد بررسی قرار خواهد داد.
فهرست مطالب
Toggleمیکروارگانیسم چیست؟
از جمله آلایندههای متداول در پسابهای بهداشتی و صنعتی، انواع مواد آلی هستند که ورود آنها به محیط زیست و منابع آب زیرزمینی میتواند تهدیدی جدی برای سلامت انسان و سایر موجودات زنده به شمار آید. به همین دلیل، اقداماتی برای حذف این آلایندهها از طریق فرآیندهای مختلف انجام میشود. یکی از روشهای مؤثر و پرکاربرد در سیستمهای پکیج تصفیه فاضلاب انسانی و صنعتی، تصفیه بیولوژیکی است. در این روش، میکروارگانیسمها برای حذف مواد آلی به کار گرفته میشوند. این میکروارگانیسمها مواد آلی را به عنوان منبع غذایی خود مصرف کرده و در نتیجه رشد و تکثیر مییابند. با توجه به نوع تجهیزات و فرآیندهای تصفیه، و همچنین اینکه میکروارگانیسمها هوازی یا بیهوازی هستند، ممکن است در حین تجزیه مواد آلی، لجن و گاز متان نیز تولید گردد.
انواع میکروارگانیسم های تصفیه فاضلاب
میکروارگانیسمهای مورد استفاده برای حذف مواد آلی از فاضلاب بر اساس ساختار و شیوه زندگیشان به گروههای مختلفی تقسیم میشوند. از مهمترین این گروهها میتوان به گزینههای زیر اشاره کرد:
باکتری
باکتریها از مهمترین میکروارگانیسمها در فرآیند تصفیه فاضلاب صنعتی و بهداشتی به شمار میروند و شامل انواع مختلفی از جمله هوازی، بیهوازی و دوگانهزی هستند. باکتریهای هوازی برای رشد و تکثیر خود از مواد آلی موجود در فاضلاب به عنوان منبع غذایی استفاده کرده و اکسیژن مورد نیازشان را از طریق هوادهی فاضلاب تأمین میکنند. این باکتریها را میتوان بر اساس نوع تغذیهشان به دو گروه کلی تقسیم کرد:
هتروتروپیک
هتروتروپیک به نوعی از باکتریها و میکروارگانیسمها در فرآیند تصفیه فاضلاب اشاره دارد که به سه دسته هوازی، بیهوازی و دوگانهزی تقسیم میشوند. ویژگی بارز این باکتریها، مصرف و تغذیه از مواد آلی است که به همین دلیل در تصفیه بیولوژیکی مورد استفاده قرار میگیرند. نوع بیهوازی این میکروارگانیسمها در فرآیندهایی مانند UASB، رآکتور تصفیه بیهوازی UAFB، رآکتور بافلدار بیهوازی ABR و رآکتورهای بیهوازی با رشد ثابت FBR به کار میروند.
هتروتروپیکهای هوازی برای رشد و تکثیر به اکسیژن نیاز دارند و در فرآیندهای تصفیه فاضلاب، از دیوفیوزرها یا هوادههای عمقی استفاده میشود. روشهای رایج شامل لجن فعال با جریان پیستونی (CPF)، لجن فعال اختلاط کامل (CMAS)، تثبیت تماسی (CSAS) و هوادهی گسترده (EAAS) میباشند. این میکروارگانیسمها از مواد آلی به عنوان منبع غذایی استفاده میکنند و قادر به تصفیه مواد معدنی نیستند. نوع دوگانه زی هتروتروپیکها میتوانند در هر دو شرایط رشد و تکثیر نمایند.
اوتوتروپیک
این نوع باکتریها مواد معدنی موجود در فاضلاب را مصرف کرده و آنها را به اکسید تبدیل میکنند. با توجه به اینکه اکسید تولید شده توسط این باکتریها ممکن است باعث خوردگی تجهیزات فاضلاب شود، استفاده از آنها در صنعت تصفیه فاضلاب محدودیتهایی دارد.
قارچ
قارچها یکی از میکروارگانیسمهای مهم در فرآیند تصفیه فاضلاب هستند و در دسته ارگانیسمهای هوازی قرار میگیرند. این میکروارگانیسمها برای رشد و تکثیر به مواد آلی نیاز دارند و به این ترتیب میتوانند در تصفیه بیولوژیکی فاضلاب نقش مؤثری ایفا کنند. با این حال، باید توجه داشت که تأثیر قارچها در تصفیه فاضلاب زمانی مثبت است که به توده غالب میکروبی تبدیل نشوند، زیرا این امر میتواند منجر به مسدود شدن صافیها و تجهیزات تصفیهخانه شود. علاوه بر این، قارچها ممکن است در مرحله تهنشینی پس از حوضچه هوادهی مشکلات مختلفی به وجود آورده و شرایط بیهوازی را ایجاد کنند.
پروتوزوآ
پروتوزوآ به دستهای از موجودات تکسلولی اطلاق میشود که اندازه آنها کمتر از 99 میکرومتر است و در فرآیند تصفیه بیولوژیکی لجن فعال به کار میروند.نوعی از این موجودات که در تصفیه فاضلاب و آب با استفاده از صافی به کار میروند، غیر بیماریزا هستند. با این حال، برخی از گروههای پروتوزوآ مانند آمیبها میتوانند باعث بروز بیماریهای گوارشی شوند و در فرآیند تصفیه فاضلاب کاربردی ندارند.
روتیفرها
روتیفرها نوعی میکروارگانیسم چندسلولی هستند که در تصفیه فاضلاب بهکار میروند و به صورت هوازی عمل میکنند. این میکروارگانیسمها معمولاً در مراحل پایانی فرآیند تصفیه با لجن فعال مورد استفاده قرار میگیرند و به تغذیه باکتریهای معلق میپردازند.
مزایای میکروارگانیسم ها در تصفیه فاضلاب
میکروارگانیسمهای حاضر در سیستمهای تصفیه، دارای فواید متنوعی هستند که شامل موارد زیر میباشد:
تجزیه و حذف ترکیبات آلی: میکروارگانیسمها توانایی تجزیه و متابولیزه کردن ترکیبات آلی موجود در فاضلاب را دارند که این امر به کاهش بار آلی فاضلاب منجر میشود.
حذف ترکیبات معدنی مضر: برخی از میکروارگانیسمها، از جمله باکتریهای نیتریفیکاسیون و دنیتریفیکاسیون، توانایی حذف ترکیبات نیتروژن و فسفر را از فاضلاب دارند.
حذف فلزات سنگین: میکروارگانیسمهایی مانند قارچها میتوانند فلزات سنگین را جذب و رسوب دهند و به این ترتیب این ترکیبات را از فاضلاب حذف کنند.
کاهش بیماریزایی: میکروارگانیسمهای غیربیماریزا در فاضلاب به کاهش تعداد میکروارگانیسمهای بیماریزا کمک کرده و سلامت پساب تصفیهشده را افزایش میدهند.
تولید لجن زنده: در فرآیند تصفیه، میکروارگانیسمها لجن زندهای تولید میکنند که بخش اصلی لجن را تشکیل میدهد و میتواند به عنوان کود مورد استفاده قرار گیرد.
افزایش کارایی تصفیه: مدیریت و کنترل صحیح میکروارگانیسمها در سیستمهای تصفیه فاضلاب، به افزایش کارایی فرآیند تصفیه و بهبود کیفیت پساب خروجی منجر میشود.
تصفیه فاضلاب به وسیله میکروارگانیسم ها چگونه است؟
فرآیندهایی که در آن میکروارگانیسمها و باکتریهای هوازی و بیهوازی به تجزیه مواد آلی موجود در فاضلاب پرداخته و آنها را حذف میکنند، به عنوان فرآیندهای بیولوژیکی تصفیه فاضلاب شناخته میشوند. میکروارگانیسمهای طبیعی دارای ویژگیهای متنوعی هستند و در واکنش به وجود اکسیژن هوا، رفتارهای متفاوتی از خود نشان میدهند. برخی از این میکروارگانیسمها با استفاده از اکسیژن، مواد آلی را تجزیه کرده و مصرف میکنند و به این ترتیب رشد و تکثیر مییابند. در مقابل، گروه دیگری از باکتریها و میکروارگانیسمها در شرایط بیهوازی عمل کرده و با هیدرولیز مواد آلی، اسید و استات تولید کرده و در نهایت متان تولید میکنند. نوع واکنش این باکتریها نسبت به اکسیژن هوا، موجب شده است که در تصفیه فاضلاب از روشهای مختلف و تحت عنوان فرآیندهای تصفیه بیولوژیکی استفاده شود.
آرکا گستر رسام ارائه دهنده انواع پکیج های تصفیه فاضلاب
در حال حاضر، بسیاری از تصفیهخانههای فاضلاب از میکروارگانیسمها و باکتریها برای بهبود فرآیند تصفیه استفاده میکنند. انتخاب صحیح این میکروارگانیسمها از اهمیت بالایی برخوردار است، زیرا این انتخاب به شرایط جغرافیایی هر پروژه بستگی دارد. شرکت آرکا گستر با استفاده از تیمی از تکنسینهای متخصص، بهترین پکیجهای تصفیه فاضلاب را در انواع مختلف شامل پکیج تصفیه فاضلاب کامپوزیتی، پلیاتیلنی و پکیچ تصفیه فاضلاب فلزی طراحی و تولید میکند. برای آگاهی از ویژگیهای مختلف پکیجهای تصفیه فاضلاب و تجهیزات مورد نیاز، همچنین دریافت مشاوره رایگان در این زمینه، میتوانید با کارشناسان ارکا گستر تماس بگیرید.